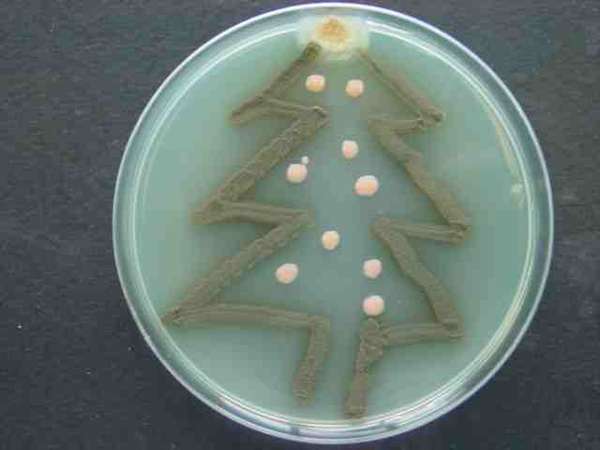

Microbial Art: Hold the Lysol! Wouldn’t you like these contagious baubles hanging from your Christmas tree?
• Alexander Fleming not only discovered penicillin (for which he won the Nobel Prize), but was also one of the first to make bacterial art (Image #4).
• Creative advertising offered by CURB, uses glow-in-the-dark bacteria to write your message (Image #5).
• Einstein “photo” was created by projecting light onto genetically engineered bacterial “film” –infused with a sugar that turns black when digested. The bacteria in the dark parts of the Petri dish digested this sugar and so turned black, whereas in the illuminated areas, a light-activated gene prevented the bacteria from eating the sugar, and so these parts remained clear (Image #6).
More awesome art: http://www.newscientist.com/gallery/microbe-art/1
http://www.trendhunter.com/trends/curb-discofungi

love these, bacteria can be beautiful
Yes, Szilveszter Liszy , the snowman and tree are fungi, the rest are bacteria 🙂
They are organic… for sure.
merry x’mass
Very Very Happy Merry Christmas
Innovative..